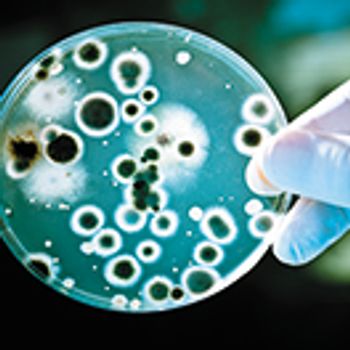

Pharmaceutical Executive
As CAR-T therapy eyes new territory-solid tumors-and expands into autoimmune disease, other frontiers in drug development are beginning to open up. They highlight the raw promise of science, with cannabis-based agents targeting CNS and rare genetic disorders, as well as the larger responsibility to public health, including advancing non-opioid alternatives, addressing antibiotic, and untangling the path to market for biosimilars.








